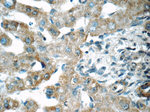
SENP1 Antibody in Immunohistochemistry (Paraffin) (IHC (P))

Search
Proteintech
SENP1 Polyclonal Antibody
{{$productOrderCtrl.translations['antibody.pdp.commerceCard.promotion.promotions']}}
{{$productOrderCtrl.translations['antibody.pdp.commerceCard.promotion.viewpromo']}}
{{$productOrderCtrl.translations['antibody.pdp.commerceCard.promotion.promocode']}}: {{promo.promoCode}} {{promo.promoTitle}} {{promo.promoDescription}}. {{$productOrderCtrl.translations['antibody.pdp.commerceCard.promotion.learnmore']}}
产品信息
25349-1-AP
种属反应
宿主/亚型
分类
类型
抗原
偶联物
形式
浓度
规格
纯化类型
保存液
内含物
保存条件
运输条件
产品详细信息
Immunogen sequence: MDDIADRMR MDAGEVTLVN HNSVFKTHLL PQTGFPEDQL SLSDQQILSS RQGHLDRSFT CSTRSAAYNP SYYSDNPSSD SFLGSGDLRT FGQSANGQWR NSTPSSSSSL QKSRNSRSLY LETRKTSSGL SNSFAGKSNH HCHVSAYEKS FPIKPVPSPS WSGSCRRSLL SPKKTQRRHV STAEETVQEE EREVYRQLLQ MVTGKQFTIA KPTTHFPLHL SRCLSSSKNT LKDSLFKNGN SCASQIIGSD TSSSGSASIL TNQEQLSHSV YSLSSYTPDV AFGSKDSGTL HHPHHHHSVP HQPDNLAASN TQSEGSDSVI LLKVKDSQTP TP (1-331 aa encoded by BC045639)
靶标信息
SENP1 is a protease that catalyzes two essential functions in the SUMO pathway: processing of full-length SUMO1, SUMO2 and SUMO3 to their mature forms and deconjugation of SUMO1, SUMO2 and SUMO3 from targeted proteins. SENP deconjugates SUMO1 from HIPK2 and from HDAC1, which decreases the transcriptional repression activity of the latter.
仅用于科研。不用于诊断过程。未经明确授权不得转售。
生物信息学
蛋白别名: SEN1; Sentrin-specific protease 1; Sentrin/SUMO-specific protease SENP1; SUMO1/sentrin specific peptidase 1; SUMO1/sentrin specific protease 1; unnamed protein product
基因别名: SENP1; SuPr-2
UniProt ID: (Human) Q9P0U3
Entrez Gene ID: (Human) 29843